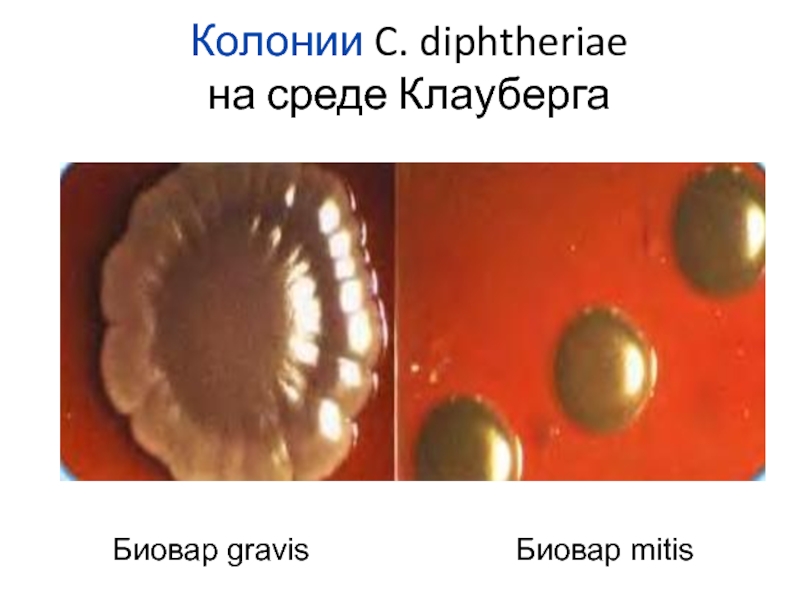
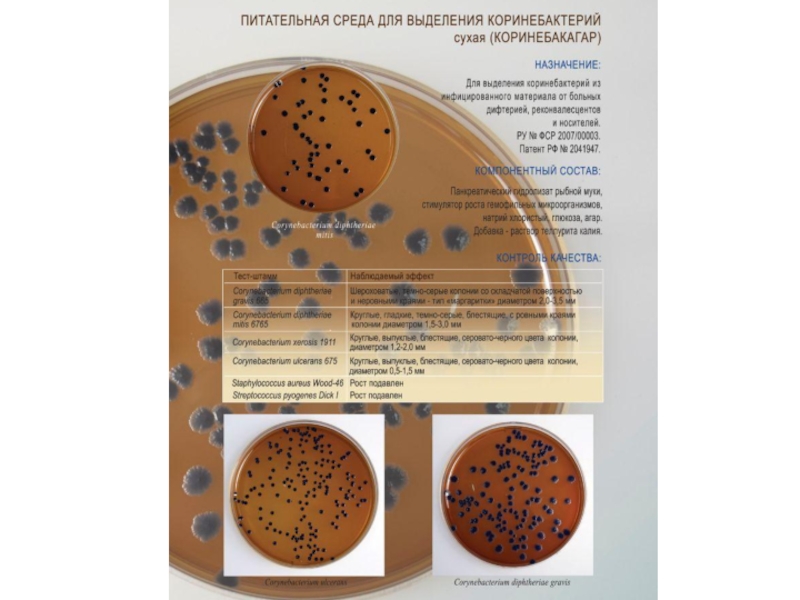
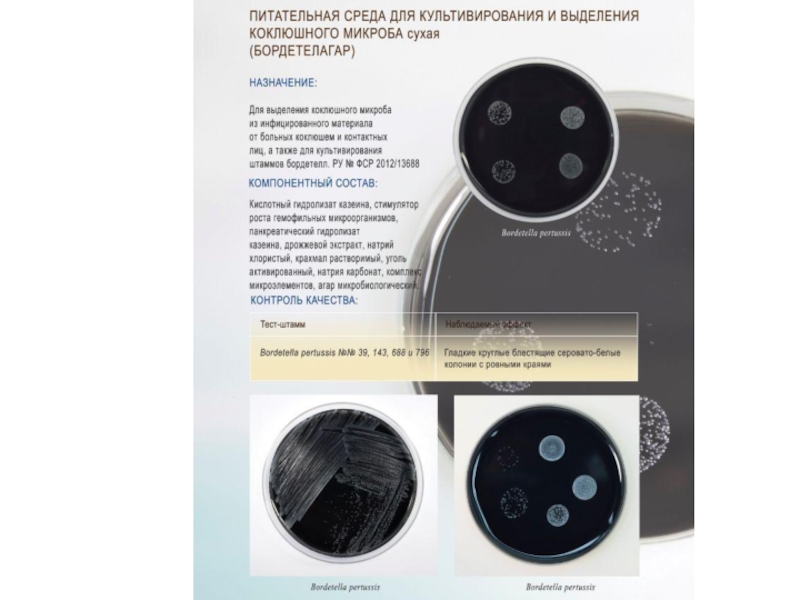

- Главная
- Разное
- Дизайн
- Бизнес и предпринимательство
- Аналитика
- Образование
- Развлечения
- Красота и здоровье
- Финансы
- Государство
- Путешествия
- Спорт
- Недвижимость
- Армия
- Графика
- Культурология
- Еда и кулинария
- Лингвистика
- Английский язык
- Астрономия
- Алгебра
- Биология
- География
- Детские презентации
- Информатика
- История
- Литература
- Маркетинг
- Математика
- Медицина
- Менеджмент
- Музыка
- МХК
- Немецкий язык
- ОБЖ
- Обществознание
- Окружающий мир
- Педагогика
- Русский язык
- Технология
- Физика
- Философия
- Химия
- Шаблоны, картинки для презентаций
- Экология
- Экономика
- Юриспруденция
Лабораторная диагностика дифтерии и коклюша презентация
Содержание
- 1. Лабораторная диагностика дифтерии и коклюша
- 2. КЛАССИФИКАЦИЯ КОРИНЕБАКТЕРИЙ ПОРЯДОК
- 3. МАЗОК ИЗ КУЛЬТУРЫ C. diphtheriae
- 4. Среда Клауберга II Питательный агар Теллурит
- 5. Колонии C. diphtheriae на среде Клауберга Биовар gravis Биовар mitis
- 7. ОСНОВНЫЕ ФАКТОРЫ ПАТОГЕННОСТИ C. diphtheriae
- 8. Коринетоксагар предназначен для определения токсигенности дифтерийных микробов.
- 10. РНГА (РОПГА) для выявления дифтерийного токсина
- 11. Положительная проба Пизу на наличие цистиназы В
- 12. Проба на наличие уреазы C. diphtheriae
- 13. Определение активности нитратредуктиазы Тест позволяет определить
- 15. БАКТЕРИОЛОГИЧЕСКИЙ МЕТОД
- 16. Исследуемый материал (отделяемое слизистой зева, носа и
- 17. 1 день Зев
- 18. Протокол. Лабораторная диагностика дифтерии
- 20. Показания для применения. Лечение больных дифтерией.
- 21. Гастон Рамон (1886-1963) Культуру бактерий, продуцирующих экзотоксин,
- 22. Вакцины, содержащие дифтерийный анатоксин АКДС АДС-анатоксин АДС-М-
- 23. Тетракок Тетракок - вакцина для комбинированной профилактики
- 24. Пентаксим® содержит антигены дифтерийного и столбнячного анатоксина,
- 25. Инфанрикс ИПВ - ацеллюлярная вакцина для профилактики: Дифтерии,
- 26. Инфанрикс Пента - ацеллюлярная вакцина для профилактики: Дифтерии,
- 27. Инфанрикс Гекса -ацеллюлярная вакцина для профилактики: Дифтерии,
- 28. Б О Р Д Е Т Е
- 29. Мазок из чистой культуры B. рertussis, окраска по методу Грама
- 30. Рост колоний B. рertussis на кровяном агаре
- 35. Забор материала от больного
- 36. Борде — Жангу среда плотная
- 37. Вакцины, содержащие коклюшный компонент
- 38. Протокол. Лабораторная диагностика коклюша
Слайд 2КЛАССИФИКАЦИЯ КОРИНЕБАКТЕРИЙ
ПОРЯДОК Actinomycetales
СЕМЕЙСТВО Corynebacteriaceae
РОД Corynebacterium
ВИДЫ
ВОЗБУДИТЕЛЬ ДИФТЕРИИ
C. diphtheriae
БИОВАРЫ:
gravis
mitis
intermedius
C. pseudotuberculosis
верхние дыхательные пути
поверхность кожи
урогенитальный тракт
C. pseudodiphtheriticum
верхние дыхательные пути
поверхность кожи
C. xerosis
поверхность кожи
урогенитальный тракт
C.аmycolactum
урогенитальный тракт
Corynebacterium non diphtheriae
Слайд 4Среда Клауберга II
Питательный агар
Теллурит калия
Глицериновая смесь
Лаковая кровь
Кровяной теллуритовый агар (КТА)
Питательный агар
Теллурит
Дефибринированная или гемолизированная кровь
СРЕДЫ ДЛЯ ПЕРВИЧНОГО ПОСЕВА ИССЛЕДУЕМОГО МАТЕРИАЛА
Слайд 8Коринетоксагар
предназначен для определения токсигенности дифтерийных микробов.
Состав: панкреатический гидролизат минтая, натрия хлорид, натрия
Слайд 9
Ат
Ат
Ат
Ат
Ат
Аг (экзотоксин)
Аг
Аг
Аг
Аг
Аг
Аг
Аг
Токсигенная
культура
Токсигенная
культура
Нетоксигенные
культуры
Диск, пропитанный антитоксином диагностическим дифтерийным
«Усы» преципитации (Аг+АТ)
Слайд 10РНГА (РОПГА) для выявления дифтерийного токсина
Диагностикум эритроцитарный дифтерийный
антительный жидкий для определения
Штаммы коринебактерий дифтерии засевают в жидкую питательную среду и инкубируют при 37° C в течение
18 часов, используют надосадочную жидкость среды культивирования
Через 2,5 - 3,5 часа производят учет результатов реакции. Допускается - через 18 - 24 часа.
токсин
Слайд 11Положительная проба Пизу на наличие цистиназы
В составе питательной среды:
цистин и уксусно
Цистиназа расщепляет цистин, выделяется сероводород , который взамодействуя с индикатором, образует серно - кислый свинец - соединение темно - коричневого цвета.
Инкубация 37 ̊С – 24 часа
Ускоренный метод - большое количество культуры – 3 часа.
Слайд 12 Проба на наличие уреазы
C. diphtheriae
не имеет уреазы
В составе питательной
Уреаза расщепляет мочевину с образованием аммиака и углекислоты.
Повышается pH среды - покраснение индикатора.
При отсутствии фермента среда остается желтой.
Ускоренная проба Заксе: 37 ̊С – 30 мин.
Бульон с мочевиной: 37̊С – 24 часа
Слайд 13Определение активности нитратредуктиазы
Тест позволяет определить способность восстанавливать нитраты в нитриты.
Слайд 16Исследуемый материал
(отделяемое слизистой зева, носа и
из места атипичной локализации
Тампоны должны
Слайд 171 день
Зев Нос
24 часа
2 день
Постановка
токсигенность, цистиназу
48 часов /3 день
Посев на:
сахарозу
глюкозу
крахмал
мочевину
72 часа / 4 день
Учет свойств
Определение биохимического варианта
Учет
Слайд 18Протокол. Лабораторная диагностика дифтерии
1)____________________
______________________
______________________
______________________
______________________
______________________
______________________
2)
Слайд 21Гастон Рамон
(1886-1963)
Культуру бактерий, продуцирующих экзотоксин, выращивают в жидких питательных средах для
дифтерийный анатоксин
Слайд 22Вакцины, содержащие дифтерийный анатоксин
АКДС
АДС-анатоксин
АДС-М- анатоксин
АД-М-анатоксин
Д.Т. Вакс (дифтерия, столбняк)
БУБО-Кок (дифтерия, столбняк, коклюш,
Слайд 23Тетракок
Тетракок - вакцина для комбинированной профилактики дифтерии, столбняка, коклюша и полиомиелита
1 доза вакцины Тетракок (0,5 мл) содержит:
очищенный дифтерийный анатоксин,
очищенный столбнячный анатоксин
Bordetella pertussis,
инактивированные вирусы полиомиелита 1,2,3 типов,
гидроокись алюминия,
формальдегид,
фенолэтанол.
Слайд 24Пентаксим® содержит антигены дифтерийного и столбнячного анатоксина, компоненты клеточной стенки возбудителя
Разовая доза составляет 0,5 мл.
Профилактика у детей от 3-х месяцев до 3 лет 11 месяцев 29 дней.
Слайд 25Инфанрикс ИПВ - ацеллюлярная вакцина для профилактики:
Дифтерии, коклюша, столбняка, полиомиелита
Состав: ДT, СT, 3 Ag коклюшного микроба (КT+ФГA+ПРT),
3 инактивированных вируса полиомиелита
(тип 1, 2, 3)
Слайд 26Инфанрикс Пента - ацеллюлярная вакцина для профилактики:
Дифтерии, коклюша, столбняка,
полиомиелита,
Состав: ДT, СT, 3 Ag коклюша (КT+ФГA+ПРT), 3 инактивированных вируса полиомиелита (тип 1, 2, 3), очищенный HBsAg
Слайд 27Инфанрикс Гекса -ацеллюлярная вакцина для профилактики:
Дифтерии, коклюша, столбняка,
полиомиелита, гепатита В,
Состав: ДT, СT, 3 Ag коклюшного микроба (КT+ФГA+ПРT), 3 инактивированных вируса полиомиелита (тип 1, 2, 3), очищенный HBsAg,
коньюгат капсульного
полисахарида Hib
Слайд 28Б О Р Д Е Т Е Л Л Ы
РОД
ВИДЫ
B. pertussis
B. parapertussis
B. bronchiseptica
B. avium
Слайд 36
Борде — Жангу среда
плотная питательная среда для культивирования гемоглобинофильных бактерий, представляющая
Среда Казеиново-угольный агар (КУА)
кислотный гидролизат казеина глубокой степени расщепления
крахмал растворимый
уголь активированный
дрожжевой диализат
калий фосфорнокислый однозамещенный
магний хлористый
кальций хлористый
медь сернокислая
кислота глутаминовая
цистеин
агар микробиологический